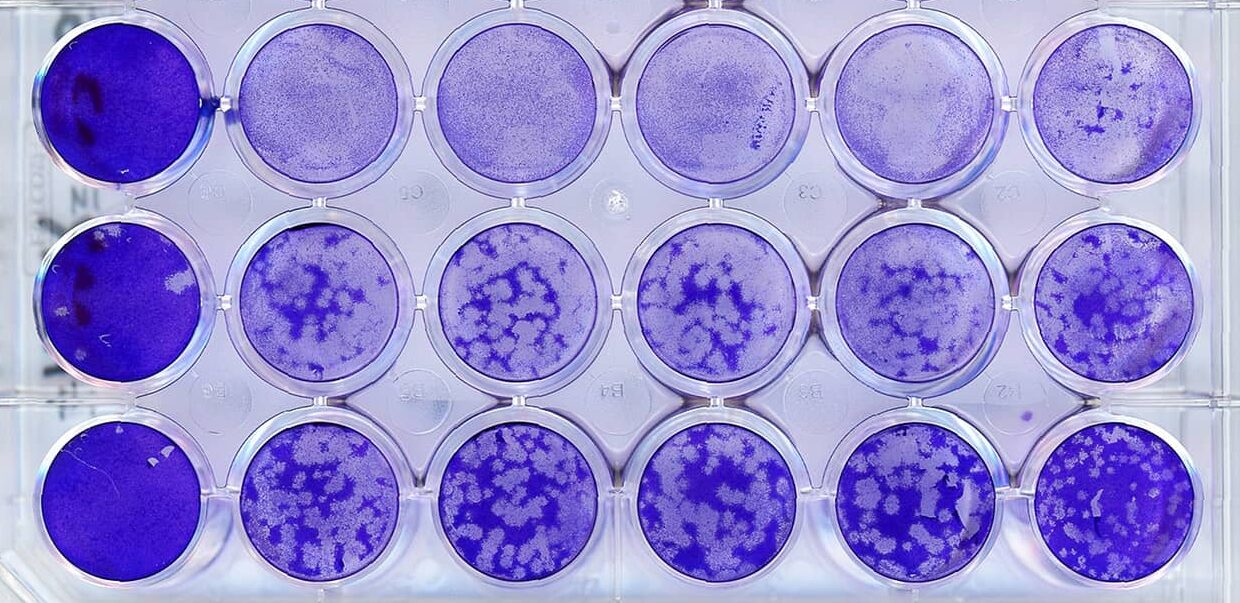

Inaugural Symposium of the “Cell Cycle & Cancer” axis
Registration here
13-ZOMES & 11th Proteasome Joint Meeting – 27-30 April 2026 in Montpellier
Registration and Program here

Annual Symposium of the Infection & Immunity axis: « Interferon in health and disease »
Thursday February the 5th 2026, Balard Amphitheater
Registration mandatory until January 12th here
Symposium of the “Cell Membrane & Cytoskeleton” axis on October 22nd 2025
Find our program here


Association Docs & Post-docs CIIGALES
In July 2024, the young scientists of BIOLuM founded the CIIGALES association (CRBM, IRIM and IGMM Association for Lunaret’s Emerging Scientists). All individuals recruited for a minimum of six months and conducting research in one of the four BIOLuM units are automatically members for the full duration of their contract.
The association has set itself the following objectives: (i) to organize social events fostering connections within BIOLuM, (ii) to coordinate scientific meetings and research days, (iii) to facilitate exchanges across all components of the research community, (iv) to support and assist its members in the event of difficulties or conflicts, and (v) to welcome and integrate new members. Find all the information here.
Open Day for Master Students on Septembre 3rd 2025
We welcomed Master’s students from the Biology–Health track, as well as students from the Biotin and Infection Biology Master’s programmes, for a half-day open house (2:00–6:00 pm).
We introduced them to the seven research areas of the BIOLuM units, as well as the technological platforms available on our campus (MRI and ZEFIX).
This presentation was followed by informal discussions between students and supervisors in front of posters and within the laboratories.